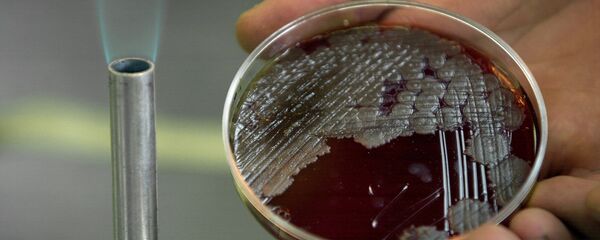
بكتيريا - سبوتنيك عربي

وقام العلماء، خلال تجاربهم، بدراسة 100 منشفة تم استخدامها لمدة شهر، حيث جمعوا البكتيريا المتراكمة عليهم وقاموا بتحديد نوعها باستخدام الاختبارات البيوكيميائية، ونشروا نتائج دراستهم على موقع "urekAlert".
ووجد العلماء أن 49% من المناشف، التي تم فحصها، أظهروا نموا مضطردا للبكتيريا مع عدد أفراد العائلة. وعلاوة على ذلك، فإن المنشفات التي تستخدم في تجفيف الأيدي والصحون وأدوات المطبخ ملوثة بشكل أكبر من المناشف التي تستخدم لمرة واحدة فقط. في نفس الوقت، كانت المناشف المبللة أكثر خطورة على صحة الإنسان من الجافة.
ومن بين البكتيريا التي تم العثور عليها، 36.7% بكتيريا القولون و36.7 مكورات معوية و14.3 من المكورات العنقودية الذهبية، حيث تكثر لدى الأسر التي لديها عدة أطفال، وذات وضع اجتماعي واقتصادي منخفض.
وأكد العلماء أن جميع أنواع البكتيريا التي تم العثور عليها يمكن أن تسبب اضطراب المعدة إذا ما تم تناولها.